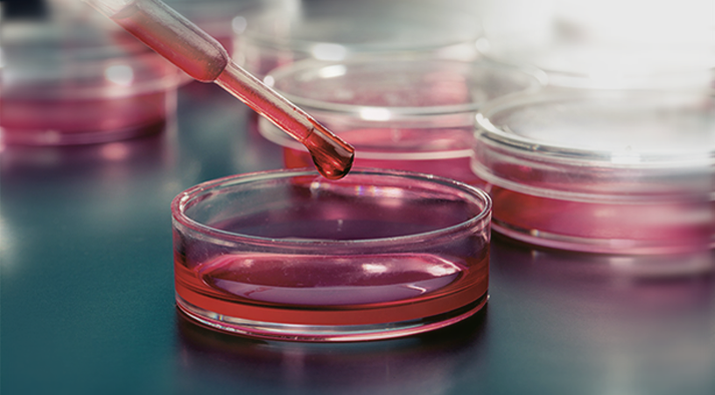

1. 기업개요
시너지이노베이션은 바이오기술사업, 의료기기 제조 및 수입판매 사업(엠아이텍), 건강기능 식품사업(노비스바이오) 등을 영위하고 있으며 혈당측정 시험지와 측정기기의 모든 생산라인 시설을 보유 중이다.
또한 소화관용 스텐트를 국내 최초로 개발하였으며 생산 품목군을 다양화하여 악성 종양뿐만 아니라 양성의 경우에도 사용을 늘리고 있으며 동물용 스텐도 판매 중이다.
2. 최근 주가 흐름

급등 후 조정.. 급등 후 조정...
급등 후 조정을 거치며 계속해서 우상향하고 있다.
흐름을 잘 파악하면 단타 종목으로 가져가기에 좋은 주식인 것 같다.
3. 기업실적
1. 시가총액 : 3,789억
2. 시가총액순위 : 273억
3. 21년 1분기 매출액 : 188억
2. 21년 1분기 영업이익 : 37억
3. 21년 1분기 순이익 : 31억

<주요 제품 매출>

급등주? 테마주? 정도로만 생각한 회사였는데 부채비율도 상당히 낮고 실적이 꾸준히 좋아지고 있는 중소형 기업이다.
관심 목록에 넣어두고 꾸준히 체크하며 지켜봐야겠다.
4. 투자포인트
시너지이노베이션 주가가 갑작스레 시간 외 급등하였다. 왜 급등하였을까?
아직 정확하게 알 수 없지만 투자자들은 보건복지부 장관의 브리핑과 관련해서 올랐다고 분석하고 있다.
보건복지부 장관은 브리핑에서 삼성바이오로직스가 8월 말부터 모더나 백신의 완제품 시생산을 계획하고 있다고 발표하였다.
삼성바이오로직스의 모더나 생산과 시너지이너베이션과의 관계는??
모더나 백신을 생산하기 위해서는 미생물 배양시설을 보유해야 한다.
그렇기에 삼성바이오로직스에 미생물 배양 배지를 납품하고 있는 시너지이노베이션이 같이 수혜를 받을 것이라는 전망에 급등하였다.
5. 회사소개
시너지이노베이션 및 그 종속회사는 바이오기술사업(시너지이노베이션 바이오사업부문), 의료사업부문(엠아이텍), 건강기능식품사업(노비스바이오)으로 구성되어 있다.
<시너지이노베이션 및 종속회사 사업내용>

바이오기술사업
국내 최초로 120여 종의 미생물 배양용 배지를 대량 상산, 판매하는 배지 전문업체 코메드생명과학(주)를 흡수 합병하여 만들어진 (주)시너지이노베이션 바이오사업본부는 전국 대부분의 병원, 검사센터 및 제약회사 등에 고품질의 생배지와 표준균주를 공급하고 있다. 또한 체외진단 분석기용 시약의 하나이며 의약품 제조환경의 환경 모니터링용으로 널리 쓰이는 미생물배양배지를 최고의 제조환경과 엄격한 품질기준에 맞게 생산하기 위하여 Clean Room 및 자동화 생산라인을 갖추고 ISO13485 국제 인증과 의료기기 GMP 인증을 획득한 제조환경에서 제품을 생산, 공급하고 있다.
신약개발사업
서울대학교 산학협력단과 차세대 치료제로 각광받고 있는 유전자치료제 관련 원천 특허 3건을 양수 완료해 신약개발의 기반을 마련하였다. 새로운 전달 방식을 이용한 폐암치료제와, 금나노 셀을 이용한 피부암 치료제, 유방암 치료응용기술을 확보해 향후 유전자치료제 개발에 적극 활용할 예정이다.

6. 투자자별 매매동향

7. 최근 이슈
시너지이노베이션 이낙연 관련주??
시너지이노베이션 주가 상승세 이유는 이낙연 때문? - 금강일보
시너지이노베이션 주가 상승세 이유는 이낙연 때문?시너지이노베이션의 주가가 오후 갑작스럽게 상승하면서 투자자들 사이에서 화제를 모으고 있다.시너지이노베이션은 바이오기술사업, 의료
www.ggilbo.com
시너지이노베이션, 삼성바이오 모더나 백신 완제품시생산 계획에 시간 외 상한가
시너지이노베이션, 시간외 상한가…삼성바이오 모더나 백신 완제품 시생산 계획
5일 시간외 매매에서 시너지이노베이션이 상한가를 기록했다. 이날 오후 4시 40분 기준 시너지이노베이션의 주가는 종가보다 10.00% 오른 5500원에 시간외 거래되고 있다. 시너지이노베이션의 시간
www.pinpointnews.co.kr
본 글은
전자공시와 증권사 리포트 등을 참고하여 요약정리하였습니다.
회사의 개략적인 내용이니 투자하시기 전 회사의 재무 상태 및 사업내용 등을 다시 한번 확인하시고 투자하시기를 당부드립니다. 주린이의 매매일지일 뿐, 투자 추천이 아닙니다.
'증시 > 기업분석' 카테고리의 다른 글
| 크래프톤 주가 전망 기업분석 - 흥행 실패 이유 및 비전 (0) | 2021.08.10 |
|---|---|
| 코데즈컴바인 주가 전망(+투자포인트, 대북 관련주) (0) | 2021.08.09 |
| LG헬로비전 주가 전망(+투자포인트, 디즈니, 목표주가) (1) | 2021.08.05 |
| 아이비김영 주가 전망(+투자포인트, 일자리관련주) (0) | 2021.08.04 |
| 제일바이오 주가 전망(+투자포인트, 아프리카 돼지열병 관련주) (0) | 2021.08.03 |
댓글